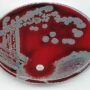
Как проявляются симптомы гонореи?

Дети подвержены простудным заболеваниям, часто болеют острыми респираторными инфекциями. Это заставляет задумываться о поиске эффективного и безопасного средства для лечения детей, быстрого снятия симптомов остро протекающей простуды.
Дети подвержены простудным заболеваниям, часто болеют острыми респираторными инфекциями. Это заставляет задумываться о поиске эффективного и безопасного средства для лечения детей, быстрого снятия симптомов остро протекающей простуды.
Сегодня существует множество всевозможных средств, предназначенных для лечения детской простуды, как для внутреннего, так и для наружного применения.
Среди наружных средств выделяется мазь для детей доктор МОМ от простуды. В ее состав входят натуральные и безопасные для детей компоненты, обеспечивающие отличный лечебный эффект.
Мазь доктор МОМ для детей от простуды применяется в составе комплексной терапии остро протекающих респираторных заболеваний, которые сопровождаются насморком, заложенностью носа, болями в мышцах, спине и головными болями.
Фармакологические свойства мази доктор МОМ
Нанесенная на кожу мазь оказывает отвлекающее, местно-разражающее, антисептическое и противовоспалительное действие. Фармакологическая характеристика препарата обусловлена компонентами, входящими в его состав.
Ментол, воздействуя на кожные покровы, вызывает расширение кровеносных сосудов, что приводит к ощущению холода, снимающему чувство боли. Камфара проявляет себя, как местное раздражающее и обезболивающее средство. Тимол играет роль антисептика с комбинированным действием против бактерий и грибков.
Эвкалиптовое и скипидарное масло исполняют роль местных раздражителей. Мускатное масло угнетающе действует на синтез простагландинов.
Показания к применению мази доктор МОМ у детей:
- Комплексная терапия острых респираторных заболеваний у детей в возрасте старше двух лет.
- Используется только как наружное средство.
- Для лечения болей в мышцах, мазью смазывают больные места и укутывают теплом.
- При головных болях мазь наносится на височную область.
- В случае ринита и заложенности носа мазь распределяют по коже крыльев носа.
- Для лечения кашля, сопровождающего простудные заболевания, мазь наносят на область грудной клетки и шею.
- Лечебные процедуры могут повторяться до трех раз в сутки. Срок лечения от 3 до 5 дней.
Препарат нельзя наносить на поврежденную кожу. Доктор МОМ мазь для детей нельзя применять при кожных заболеваниях, аллергии на входящие в ее состав компоненты. На это лечебное средство возможна аллергия, проявляющаяся крапивницей, везикулярной сыпью.
При использовании мази, следует избегать ее попадания на слизистые оболочки глаз, рта, полости носа. Хранить мазь доктор МОМ необходимо при комнатной температуре в плотно закрытой заводской упаковке.